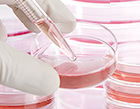
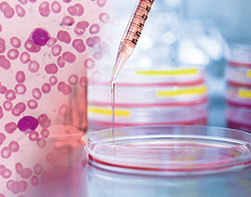

- UPDATE

THE CLINIC が選ばれている理由
国からの許可を受け再生医療を提供するクリニック
当院は細胞加工サービスの提供を国から許可されたクリニックです。正式な届出をした上で肌再生医療を提供しています。
脂肪を活用した肌のエイジング治療に特化
脂肪を専門に扱うTHE CLINIC は、脂肪幹細胞を活用した治療にも多くの実績があります。

脂肪幹細胞を冷凍保存できるシステムを確立
将来使用するために、現時点の脂肪細胞を凍結保存できる「FAT BANK」サービスを当院は展開しています。

セルチャー肌再生療法(培養幹細胞注入)の特徴
セルチャー肌再生療法(培養幹細胞注入)はご自身の脂肪から取り出した脂肪幹細胞を活用して、お肌を若返らせる治療法です。幹細胞を200〜300倍に培養させる技術と、-196℃で凍結保存する技術を掛け合わせることで、ごく少量の脂肪採取で繰り返し高濃度の脂肪幹細胞を注入できるようになりました。
自分の細胞を活用した肌の治療

加齢に伴い肌組織に必要な成分が失われることで、しわやたるみ、くすみなどの老化症状が生じることは広く知られています。この失った成分をつくり出す重要ファクターが、今、再生医療界で最も注目されている脂肪幹細胞です。
こうした流れを受けて2017年、”培養”という先端技術で約200〜300倍に増殖した幹細胞を皮膚に注入する、セルチャー肌再生療法(培養幹細胞注入)が誕生しました。物理的に手を加える美容整形ではなく、細胞治療による肌再生(皮膚の再生)で、自発的に若返る時代が到来したのです。
しかし、幹細胞が肌再生(皮膚の再生)に作用することは分かっていても、その量には限りがあります。大量の幹細胞を用意するには、同時に大量の脂肪を採取する必要があったのです。
この点、セルチャー肌再生療法(培養幹細胞注入)で必要とする脂肪量は、わずか20mL。局所麻酔で対応可能なこの大さじ1杯半程度の脂肪から、複数本のバイアル(注入剤を入れる容器)に小分けできる量の脂肪幹細胞を培養できます。(バイアル1本あたりに含まれる幹細胞の数は、約500万個です。)
- 脂肪採取から培養のプロセス
-

肌を根本から若返らせる4つの効果がある
幹細胞には、色々な細胞に分化する能力や、組織の修復に必要な成分の分泌を促す働きがあります。
例えば、真皮の70%を占め、”肌のハリを取り戻す効果”のあるコラーゲン。これまでコラーゲンは、肌組織に存在する線維芽細胞から作られるとされてきましたが、近年の研究で幹細胞も同等量のコラーゲンを産生することが確認されています。
- 脂肪幹細胞のコラーゲン産生能力
-
線維芽細胞と同等のコラーゲン産生力が確認されている
出典:ロート製薬公式サイト「Stem Science Factbook」

さらに幹細胞には、成長因子を分泌して”肌の修復を図る効果”や、抗炎症作用で”赤みを解消する効果”、血行を促進して”くすみを改善する効果”も認められています。
つまりセルチャー肌再生療法(培養幹細胞注入)には、肌を根本から若返らせる4つの効果が認められているのです。
冷凍保存で繰り返しの治療ができる

セルチャー肌再生療法(培養幹細胞注入)のメリットのひとつに、単発施術ではないということがあげられます。先にも触れたように、セルチャー肌再生療法では培養した幹細胞を複数本のバイアルに小分けしたのち、-196℃という化学変化の起き得ない環境で凍結保存します。つまり、1度の脂肪採取で、複数回の治療が可能なのです。料金にはこの複数回分の注入費用も含まれているので、注入の度に追加料金がかかることもありません。
さらに、凍結保存で注入する時点よりも若い(活性力の高い)細胞を取り込めるのも優れた特徴のひとつです。
セルチャー肌再生療法(培養幹細胞注入)の適応部位
セルチャー肌再生療法(培養幹細胞注入)では、お顔の他にも首や手の治療が可能です。シワやシミ、ニキビなどの赤みや傷跡の解消が期待できます。

幹細胞とは?
幹細胞は、特定の細胞に分化する能力を持つ細胞です。言わば、組織や臓器にもなり得る細胞のこと。世界中で様々な幹細胞が研究されていますが、代表的なものには以下の4つがあげられます。
-
- iPS細胞
- 体細胞といくつかの遺伝子でつくる人工的な幹細胞。
-
- ES細胞
- ヒトの胚(受精卵)から抽出した細胞の塊を培養する幹細胞。
-
- HS細胞
- 骨髄に存在し血球細胞に分化。白血病治療に活用。
-
- ADS細胞
- 脂肪幹細胞。HS細胞の100〜1000倍を脂肪から採取可能。
よくある質問
-
- 培養した幹細胞はどれくらいの期間、保存が可能ですか?
-
保存方法によりますが、当院のようにー196℃で保存すれば長期的な保存が可能です。若うちに脂肪を採取・幹細胞を培養しておいて、老化が気になり出してから注入する方法もお勧めしています。
-
- 他院では線維芽細胞を注入する施術があるようですが、セルチャー肌再生療法はそちらとどうちがうのでしょうか?
-
線維芽細胞が主にコラーゲンを生成するのに対し、セルチャー再生療法は同等のコラーゲンを生成するのに加え、血流を増やして肌質そのものを改善するとともに、抗炎症効果や、成長因子(肌をきれいにしろと命令するたんぱく質:コラーゲン作れ、ヒアルロン酸作れ、など)を多く出しますのであらゆる方面から美肌に効果があります。
-
- 脂肪を取るのが怖いです。
-
セルチャー肌再生療法に必要な脂肪量は、大さじ1杯半のわずか20ml。おへそや、鼠蹊部(脚の付け根)のしわなど、目立ちにくい場所から採取します。局所麻酔で対応可能な範囲ですから、ご安心ください。ほとんどの方は翌日、通常通り出勤されていますよ。
料金
|
公的医療保険等が適応されない「自由診療」となります。表示価格は全て税込です。 |
一般価格 | ローン価格医療ローンは、審査により定められた利用可能額の範囲内で、治療費を分割で返済できるサービスです。ご希望内容や審査によって異なりますので、詳しくはお問い合わせください。 |
|---|---|---|
|
||
| 培養契約料(6バイアル、1年間凍結保存) | ¥360,000 | ¥5,500/回〜 |
| 注入(1バイアル) | ¥200,000 | |
| 1バイアル追加 | ¥70,000 | |
お支払い方法
4種類のお支払い方法をご用意しております。併用していただくことも可能です。
- 現金
-
- デビットカード
- (ご利用可能金額は50万円まで)
-
- クレジットカード
-
VISA、MasterCard、JCB、American Express、Diners、DISCOVER、銀聯
※事前に限度額をご確認ください
-
- 医療ローン
-
※審査によりご利用可能金額が異なります
- <お申し込みに必要なもの>
-
- 身分証明書(下記、いずれかをご用意ください)
- 運転免許証・パスポート・健康保険証のいずれか1点
- 金融機関発行のクレジットカード、またはキャッシュカードのいずれか2点
- 銀行通帳(郵便口座可)
- 銀行届出印鑑
- 身分証明書(下記、いずれかをご用意ください)
施術概要
| 処置時間 | 脂肪採取:15〜20分 注入:20分程度 |
|---|---|
| メイク | 翌日より可能 |
| 痛み | 局所麻酔(希望者には静脈麻酔)を使用するため、施術中の痛みはほぼありません。 |
| 洗顔 | 翌日より可能 |
| シャワー | 翌日より可能 |
| 入浴 | 翌日より可能 |
関連施術

脂肪注入
自己血液療法
RF機器
注射施術
プチ整形(鼻・顎の形成)
-

-
監修医師 大橋 昌敬 (THE CLINIC 総院長 / 日本美容外科学会専門医 / 日本美容外科学会会長)
胸部外科学などで博士号を取得した後、高水準の医療技術を求められるカナダで、心臓外科医として活躍。帰国後は「女性に最高の美しさを提供したい」という思いから美容外科医に転身する。
豊胸、脂肪吸引などでトータルボディデザインができる希少なドクターであり、圧倒的な症例経験と、他院向け技術セミナーの開催をライフワークとしていることから、国内随一の技術と熱意の持ち主として知られる。また、新しい美容医療技術の探求にも熱心で、海外の最新技術を習得する努力を欠かさず、学会での発表も積極的に行なう。
当院には、多種多様な専門医・認定医・学会員が在籍しています
<専門医/認定医>
日本美容外科学会専門医(JSAS)、日本形成外科学会専門医、日本形成外科学会指導医、日本形成外科学会 再建・マイクロサージャリー分野指導医、日本形成外科学会 小児科形成外科分野指導医、日本泌尿器科学会専門医、乳房再建用エキスパンダー/インプラント 責任医師、日本頭蓋顎顔面外科学会専門医、コンデンスリッチファット(CRF)療法認定医、VASER Lipo認定医、VASER 4D Sculpt 認定医、TOTAL DEFINER by Alfredo Hoyos 認定医、サーメージ認定医、カンタースレッズ認定医、Botox VISTA認定医、Juvederm Vista認定医、ビスタバイクロスシリーズ認定医、日本胸部外科学会認定医、日本外科学会専門医、日本消化器外科学会消化器癌外科治療認定医、日本がん治療認定医機構がん治療認定医、マンモグラフィ読影認定医、日本抗加齢医学会専門医、日本麻酔科学会 指導医、蘇生法指導医、日本心臓血管麻酔学会 指導医、日本老年麻酔学会 指導医、日本専門医機構 麻酔科専門医、アメリカ心臓病協会BLS・ACLSプロバイダー、日本呼吸器外科学会認定登録医、日本呼吸器学会専門医
<所属学会>
日本外科学会、日本臨床外科学会、日本胸部外科学会、日本消化器外科学会、日本形成外科学会、日本呼吸器学会、日本内視鏡外科学会、日本泌尿器科学会、日本美容外科学会(JSAS)、日本美容外科学会(JSAPS)、日本乳癌学会、日本乳房オンコプラスティックサージャリー学会、日本内分泌外科学会、日本甲状腺外科学会、日本頭蓋顎顔面外科学会、日本麻酔科学会、日本蘇生学会、日本臨床モニター学会、日本心臓血管麻酔学会、日本老年麻酔学会、日本臨床麻酔学会、日本医療ガス学会、米国麻酔学会(ASA)、米国形成外科学会(ASPS)
本サイトは医療広告ガイドラインを遵守した情報を掲載しています
THE CLINIC では、医師監修のもと「医療広告ガイドライン」に則り、以下の2点を遵守するとともに、状況に応じた改善を適宜行っています。
1. 治療に関する体験談は掲載致しません。
2. 症例写真を掲載する際は、施術内容とリスク、および標準的な価格を必ず明記します。



肌に効果的な脂肪幹細胞。これを培養して活用するのがセルチャー肌再生療法(培養幹細胞注入)です。ごく僅かな脂肪から施術回数分の幹細胞を用意できるので、繰り返しの注入が可能で気軽に何度も治療を受けていただけます。